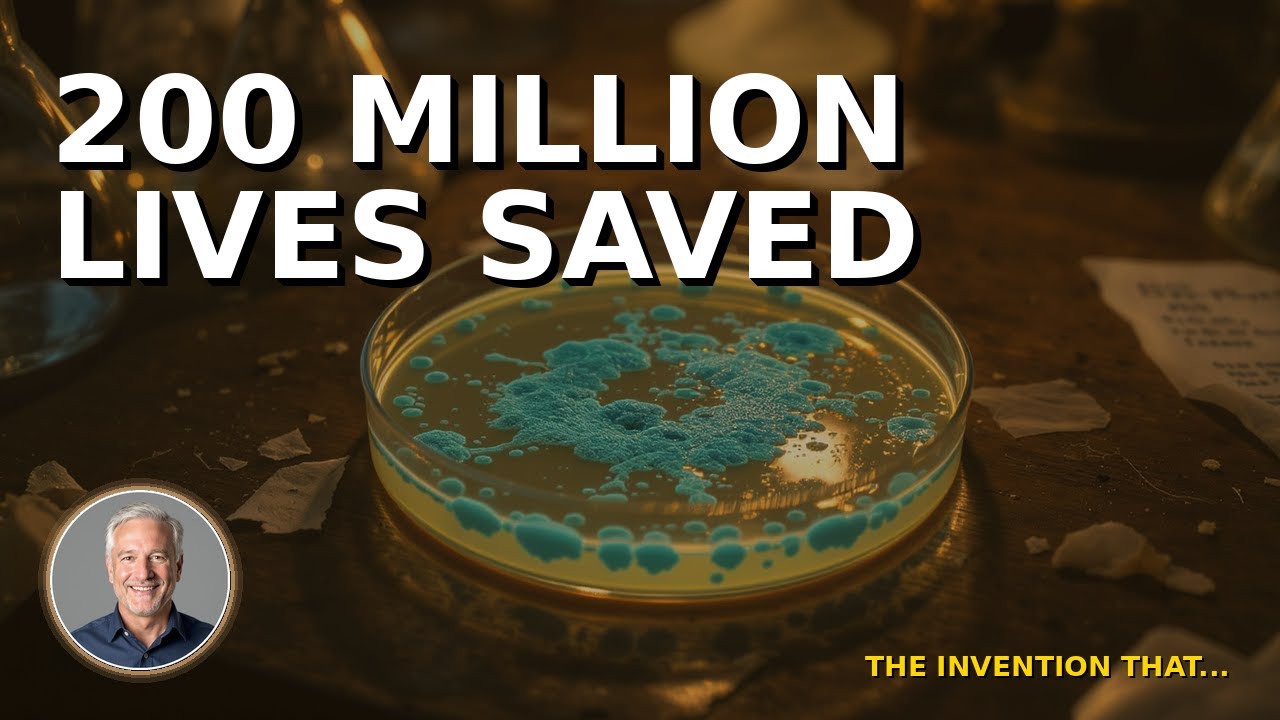
Thumbnail for A Messy Lab Accident Saved 200 Million Lives

In 1945, an engineer named Percy Spencer was standing in front of a magnetron when the chocolate bar in his pocket melted. Within two years, the first commercial microwave oven was on the market. Within five decades, ninety percent of American kitchens had one.
The Invention That Changed Everything tells the stories behind the inventions we take for granted — the accidents, the obsessions, the failures, and the moments of unexpected discovery that reshaped daily life for billions of people.
The Accidental Discovery Pattern
Many of the most consequential inventions in history were not the result of deliberate research. They were accidents. A dropped spring became the Slinky. A burr stuck to a dog’s fur became Velcro. A contaminated petri dish became penicillin. This series examines how prepared minds recognize opportunity in unexpected places.
The Human Stories
Behind every invention is a person — often an imperfect one. Richard James invented the Slinky, then abandoned his family and his fortune to join a cult in Bolivia. His wife Betty saved the company and built it into an American institution. Alfred Nobel read his own obituary in a French newspaper and was so horrified by the words “Merchant of Death” that he created the Nobel Prizes with ninety-four percent of his fortune.
These are not just stories about objects. They are stories about people who changed the world and were changed by it.
New episodes premiere every Thursday.